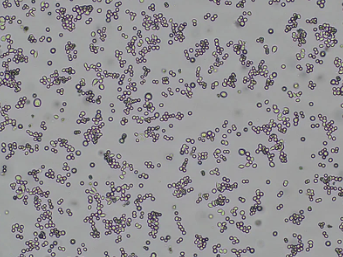

미국 Accegen은 생명과학 연구와 의약품 개발을 지원하기 위해 다양한 세포주와 생물학적 제품을 제공하는 바이오 제품 제조 기업입니다.
제품 설명
NUGC-4
제품 번호
ABC-TC0862
제품 특징
| Product Code | NUGC4; NU-GC-4 |
| Species | Human |
| Cat.No | ABC-TC0862 |
| Product Category | Tumor Cell Lines |
| Size/Quantity | 1 vial |
| Shipping Info | Dry Ice |
| Growth Conditions | 37 ℃, 5% CO2 |
| Source Organ | Lymph Node |
| Biosafety Level | 1 |
| Storage | Liquid Nitrogen |
| Product Type | Human Gastric Cancer Cell Lines |
Description
NUGC-4 is a human gastric cancer cell line derived from a 35-year-old Japanese female diagnosed with poorly differentiated adenocarcinoma containing signet ring cell carcinoma components in the metastatic paragastric lymph nodes. The cells are characterized by a spherical, epithelial-like morphology and exhibit adhesion properties, although occasional free-floating cells can be observed. They also display anchorage-independent growth, making them suitable for tumorigenicity studies. Typically cultured in PRMI1640 with 10% FBS, they show an average doubling time of 30 hours. The cells have a modal chromosome number of 52–54 in vitro and 53 in vivo. NUGC-4 cells do not express IL-1α mRNA, offering a unique gene expression profile relevant to inflammation and tumor microenvironment studies.

Citation
When you publish your research, please cite our product as “AcceGen Biotech Cat.# XXX-0000”. In return, we’ll give you a $100 coupon. Simply click here and submit your paper’s PubMed ID (PMID).
Application
As a cancer cell line, NUGC-4 is widely used to identify key factors in gastric cancer formation and targets for anti-cancer drugs.Epidermal growth factor (EGF) strongly activates the tyrosine phosphorylation in NUGC-4. Phosphatidylinositol 3-kinase (PI 3-kinase), mainly activated by tyrosine kinases, was precipitated with anti-phosphotyrosine antibodies.Exogenous hepatocyte growth factor can stimulate the proliferation of NUGC-4, and MET tyrosine kinase inhibitors inhibited this proliferation of NUGC-4.Investigation of NUGC-4 and its interactions with growth factors may guide gastric cancer signaling pathways and therapeutic target identification..
Frequently Asked Questions
NUGC-4 cells are a human gastric cancer cell line derived from a poorly differentiated adenocarcinoma. They are widely used in cancer research, particularly for studies focused on gastric carcinoma, drug screening, and understanding cancer cell biology.
Slow Growth: Ensure regular medium change, check for contamination, and avoid over-confluency.
Poor Attachment: Use properly coated culture flasks and high-quality serum.
Cell Death: Maintain optimal culture conditions, verify reagents are non-toxic, and handle cells gently.
Cell Shape: NUGC-4 cells are epithelial-like in morphology. They typically appear as polygonal or slightly elongated cells when observed under a microscope.
Adherence: They adhere well to the surface of culture flasks, forming a cobblestone-like pattern characteristic of epithelial cells.
Cytoplasm and Nucleus: The cells have a well-defined cytoplasm and prominent nuclei, which are indicative of their active proliferative state.
Accegen의 모든 제품들을 만나 보세요!
PRODUCTS
Accegen - Official Distributor in South Korea "Morebio" 한국 공식 대리점 "모아바이오"